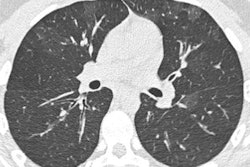

Researchers have used CT to diagnose a case of "feather duvet lung," in which lung inflammation is caused by breathing in dust from the feathers in bedding. They've warned everybody to bear in mind the condition when patients present with unexplained breathlessness.
"Healthcare professionals are typically taught to ask patients with respiratory symptoms whether they have pets at home, such as birds, but in the authors' experience, history taking does not usually extend to asking about feather exposure in duvets and pillows," noted Patrick Liu-Shiu-Cheong and colleagues from Victoria Hospital, Kirkcaldy, and Aberdeen Royal Infirmary, both in the U.K.
"This is an important omission since the use of feather, rather than synthetic, bedding is common," wrote the authors, adding that the use of feather-stuffed bedding has increased massively in the past 50 years.
"Feather duvet lung" is a form of hypersensitivity pneumonitis; it is a rare subgroup of "bird fancier's lung" and consists of an immune response, they explained in an article posted by BMJ Case Reports on 18 November. The symptoms include night sweats, a dry cough, and shortness of breath, and repeated exposure to the cause can lead to irreversible scarring of the lungs.
Imaging findings
A 43-year-old man, a nonsmoker, was referred to hospital by his general practitioner after complaining of malaise, fatigue, and breathlessness for three months.
Chest radiograph reported as normal. Note the diffuse ground-glass shadowing in all zones. Images courtesy of Dr. Patrick Liu-Shiu-Cheong, Dr. Owen Dempsey, and BMJ Case Reports 2019."Our patient's CXR [chest x-ray] report was initially reported as normal (although we disagreed)," the authors wrote. "He subsequently had a CT pulmonary angiogram with high-resolution reconstruction (to exclude pulmonary thromboembolic as well as interstitial lung disease), reported as showing a ground glass, mosaic pattern in both lungs, with borderline enlarged hilar nodes, presumed reactive."
CT scan shows mosaic pattern; apical axial view.
CT scan shows mosaic pattern; middle zones axial view.
CT scan (mediastinal axial slice) with prominent reactive borderline enlarged mediastinal and hilar nodes.Blood avian precipitins were strongly positive, and lung function testing confirmed a restrictive pattern with impaired gas transfer.
The patient had no pet birds, but on closer questioning he had recently acquired a duvet and pillows containing feathers. His symptoms, chest radiographs, and lung function tests improved after the removal of all feather bedding, and he was also given oral corticosteroid therapy.
"Our case reinforces the importance of taking a meticulous exposure history and asking about domestic bedding in patients with unexplained breathlessness," the group wrote. "Prompt recognition and cessation of antigen exposure may prevent the development of irreversible lung fibrosis."
Duvet talk
People should not rush to throw away their duvets and pillows, but they must take note if they experience breathing problems on switching to feather bedding, Dr. Owen Dempsey, co-author and consultant chest physician at the Aberdeen Royal Infirmary, told the Guardian newspaper. He thinks many cases go unnoticed.
"I suspect it is the tip of an iceberg," said Dempsey, pointing out that there are several hundred different types of hypersensitivity pneumonitis. "I think there are lots of exposures out there that we are not aware of, and just because we are not aware of them they get ignored."